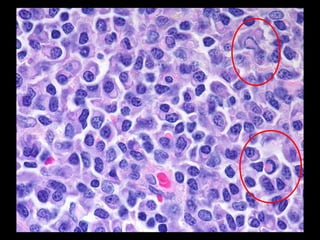
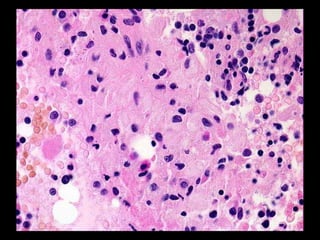

Este documento describe diferentes tipos de acumulaciones intracelulares, incluyendo acumulaciones de lípidos, proteínas, glucógeno y pigmentos. Explica las causas y significados clínicos de estas acumulaciones, así como diferentes clasificaciones como acumulaciones de colesterol, infiltración grasa, proteínas estructurales e inmunoglobulinas. También cubre acumulaciones de glucógeno, pigmentos endógenos y exógenos, y calcificación patológica.






![ESTEATOSIS (CAMBIO GRASO)
•- Existen diversas causas (toxinas,
malnutrición proteica [Kwashiorkor], diabetes
mellitus, obesidad, hipoxia) pero la causa
más común en adultos es el alcoholismo.-
•- El significado del cambio graso depende
de la causa y gravedad de la acumulación.
La esteatosis es reversible per se.-](https://image.slidesharecdn.com/acumulacionesintracelulares-121115094730-phpapp01/85/Acumulaciones-intracelulares-7-320.jpg)